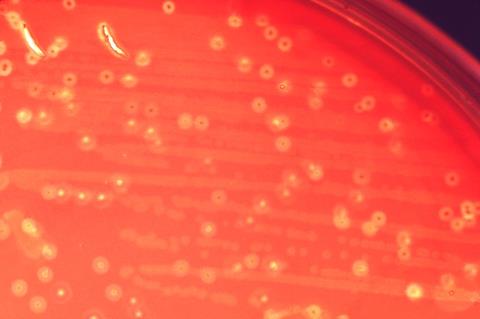
lossy-page1-800px-Streptococcus_anginosus.tif

A recent study published in the medical journal Gut has revealed a novel cancer-promoting mechanism of Streptococcus anginosus (Sa). The research shows that methionine metabolites produced by this bacterium can significantly contribute to the development of gastric cancer.
This finding deepens the understanding of the gut microbiome’s role in cancer and opens new paths for microbiota-targeted prevention strategies.
Gastric (stomach) cancer is the fifth most commonly diagnosed cancer globally, predominantly affecting East Asia (especially China, Japan, Korea) and Eastern Europe. Understanding its multifactorial causes is critical for developing effective prevention strategies.
Etiology-based prevention is a cornerstone of effective disease control. Helicobacter pylori (Hp), the first prokaryote identified as carcinogenic to humans, was classified as a Group I carcinogen by the WHO in 2017. Beyond Hp, the stomach hosts various microbes, and growing evidence links certain species to increased gastric cancer risk. This microbial association has become a key focus in cancer research. In 2022, a multi-center cohort study revealed a strong positive association between stool Sa abundance and the risk of gastric cancer. Later, a study published in Cell, a Chinese team uncovered the carcinogenic mechanism of Sa in mouse models.
Gastric cancer
Academician of the CAS Fang Jingyuan and his team at Renji Hospital, Shanghai Jiao Tong University School of Medicine, with BGI Genomics, show that Sa-derived methionine metabolites promote gastric cancer with multiple approaches. They successfully isolated Sa strains from tumor tissues and confirmed their tumor-promoting effects.
READ MORE: A common mouth and gut bacterium may be linked with increased stroke risk
READ MORE: Bacteria commonly found in the body contribute to stomach cancer, finds study
Methionine is an essential amino acid for humans. Previous studies have reported that methionine can promote the growth of various cancer cells. Mechanistically, methionine enhances the expression of MAT2A and increases its transport into cells. This process supplies energy to tumor cells and promotes their growth.
Metagenomic analysis revealed that Sa is enriched in the gut microbiota of gastric cancer patients, alongside a significant increase in the methionine biosynthesis pathway. A strong positive correlation was observed between Sa abundance and methionine levels (Figure 1). Metabolomic analysis further confirmed higher levels of methionine-related metabolites in tumor tissues.
Finding the culprits
Despite growing interest in microbial contributions to cancer, pinpointing causative bacterial strains remains a major challenge due to high species and strain-level diversity. To address this, the researchers successfully isolated and cultured three Sa strains directly from gastric tumor samples. These strains were tested and confirmed to possess methionine synthesis capabilities, alongside notable tumor-promoting effects in both mouse models and gastric cancer cell lines.
To further validate these findings, comparative genomic analysis confirmed the presence of the metE gene, essential for methionine biosynthesis, in all Sa strains. This includes strains from the Shenzhen BGI Human Gut and Oral Microbiota Repository.

This study reveals a clear link between microbial metabolism and tumor growth, highlighting bacteria-derived methionine as a key driver. Sa may serve as both a biomarker and a therapeutic target for gastric cancer. The isolated clinical strains provide a foundation for deeper research into its diversity and pathogenicity, supporting more precise prevention strategies.
Study background
Dr. Zhou Chengbei and Dr. Zhao Licong and Dr. Yu Jingchen from Renji Hospital, Shanghai Jiao Tong University, Research Scientist Dr. Qin Youwen from BGI Genomics, and Wenxi Li, a master’s graduate from BGI Education Center (supervised by Professor Zou Yuanqiang), are co-first authors of the study. Dr. Qin Youwen and Professor Fang Jingyuan (member of the Chinese Academy of Sciences) from Renji Hospital are co-corresponding authors.
By uncovering how Sa reprograms host metabolism, this study highlights the critical role of microbial metabolites in cancer development. The isolated clinical strains lay a foundation for deeper exploration of Sa diversity and pathogenicity. It offers new directions for precision prevention and control of gastric cancer.
No comments yet